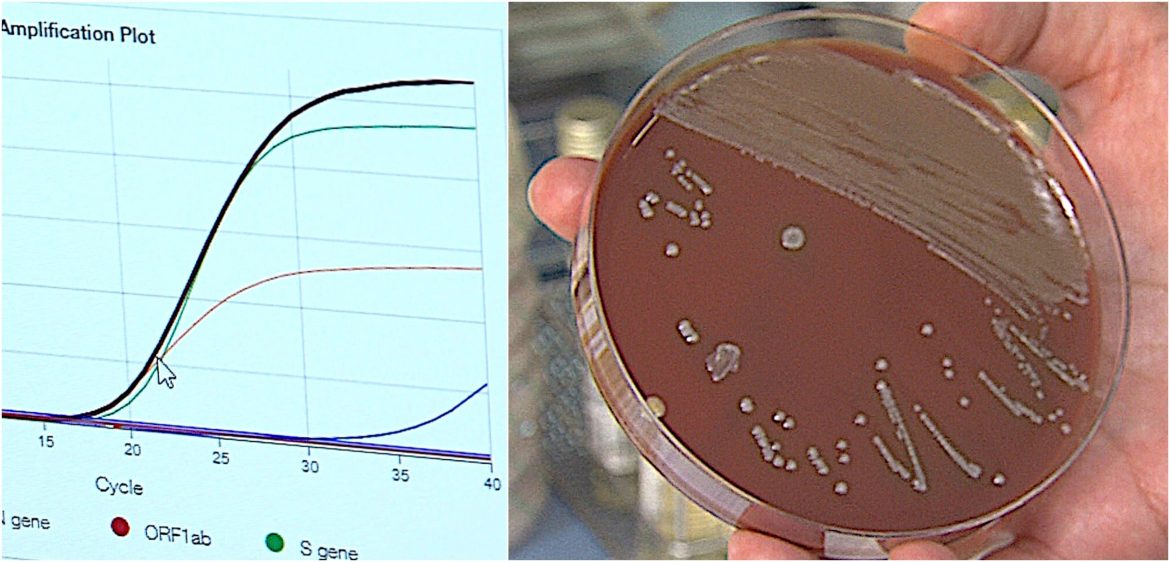
virus y bacterias_ microorganismos agentes de la neumonía-efe

El Servicio de Microbiología del Hospital Universitario de La Princesa de Madrid, dirigido por la Dra. Laura Cardeñoso Domingo, es uno de los departamentos de vanguardia de la Sanidad Pública mundial que se deja “el cuerpo y el alma, o lo que haga falta”, en defensa de la salud de todas y todos los pacientes que presentan algún síntoma infeccioso, máxime en tiempos del coronavirus.

«Buscamos un diagnóstico rápido y certero de cada dolencia, aunque sea muy complejo y laborioso», destaca la doctora Cardeñoso Domingo.
Todo el proceso analítico comienza en la ventanilla de la recepción de muestras biológicas de su laboratorio. El tubo de ensayo, etiquetado, representa vívidamente a cada persona enferma o con síntomas de una infección.
Los pacientes se han sometido previamente a una toma de muestras biológicas (orina, sangre, biopsia, esputo o exudado nasofaríngeo) para su análisis microbiológico.
«Estas muestras, sean sólidos o líquidos, pueden proceder de las Urgencias del Hospital, de Medicina Interna, de las plantas de hospitalización de pacientes de Neumología, Oncología, Hematología o de cualquier otro Servicio que lo solicite; pero durante la segunda ola de la pandemia provienen en su inmensa mayoría de los Centros de Atención Primaria de nuestra área sanitaria», dice.
Después de su registro informático, la maquinaria humana y robótica del laboratorio de Microbiología trabaja en cadena, codo con codo, para obtener la mayor eficacia posible. Los diferentes procesos y análisis buscan aislar e identificar al agente de la enfermedad, que si se trata de la neumonía tendrá su etiología localizada en las bacterias, los virus e incluso en los hongos.
Poner nombre y apellido a los microorganismos para aclarar el diagnóstico clínico de una neumonía
Muchos virus y bacterias, con una intención patológica natural, pueden conseguir que suframos una infección de nuestro sistema respiratorio si son capaces de vencer a nuestro sistema inmunológico, que siempre está en guardia frente a estos monstruos invisibles, a los que les gusta colonizar el parénquima pulmonar.
Estos microorganismos generan neumonía reduciendo sistemáticamente el intercambio gaseoso celular que se produce en los alvéolos: primero en alguno de los lóbulos pulmonares y luego multiplicándose a nivel bilateral, como un martillo pilón, hasta dejarnos sin resuello.
La neumonía, infección de las vías respiratorias bajas, tiene una amplia variedad de agentes causales que dependen del perfil de cada paciente y también del contexto epidemiológico.
«El diagnóstico microbiológico intenta identificar el agente patógeno causante de la infección y, por tanto, ajustar y dirigir el tratamiento clínico. Pero no siempre se consigue. Muchas neumonías pueden quedarse sin revelar la etiología del microorganismo», subraya la doctora Cardeñoso.

Virus y bacterias, agentes encubiertos de la neumonía
Las bacterias son microorganismos unicelulares procariotas capaces de sobrevivir y desarrollarse en cualquier ambiente y superficie, pero lo hacen de forma muy especial en el interior y en el exterior del cuerpo humano, de forma afortunadamente benévola en la mayoría de los casos.
Pero algunas bacterias nos invaden y nos hacen enfermar. Son realmente dañinas.
Según datos de la Organización Mundial de la Salud, solo en el año 2015 fallecieron alrededor de 920.000 niños y niñas por neumonía, el 15% de la mortalidad infantil de menores de hasta cinco años de vida; morbimortalidad muy prevalente en el África Subsahariana y en Asia Meridional.
En el capítulo de la neumonía adquirida en la comunidad (NAC) sobresalen las bacterias Streptococcus pneumoniae, neumococo causante del 30 al 60% de las neumonías, Streptococcus agalactiae, Enterobacterias gramnegativas, Listeria monocytogenes, Haemophilus Influenzae, Moraxella catharralis, Staphylococcus aureus, Bordetella pertussis, Streptococcus pyogenes, Chlamydia pneumoniae y Mycoplasma pneumoniae.

«La base del diagnóstico etiológico se fundamenta en la mayoría de los casos en el aislamiento del microorganismo mediante un cultivo de muestras respiratorias», explica la doctora y microbióloga María Auxiliadora Semiglia Chong.
Un cultivo bacteriano consiste en depositar parte de la muestra respiratoria sobre medios de cultivo diseñados para el crecimiento de bacterias.
«24 horas después, normalmente, en el cultivo se habrán desarrollado las bacterias patológicas junto a otros agentes que estaban en nuestro canal nasofaríngeo o en un esputo bronquial. La microbióloga tendrá que reconocer qué microorganismos son los responsables de la infección entre todos los seres vivos presentes en el cultivo», explica.
«Luego procederemos a conocer su sensibilidad antibiótica enfrentando el microorganismo patológico a diferentes tipos de antibióticos. Para ello se incorpora (inocula) una cantidad de bacteria crecida en pocillos -tubos- y se añade una cantidad determinada de antibiótico. Posteriormente se comprueba si hay presencia o ausencia de crecimiento bacteriano en dicho antibiótico».
Finalmente, se ofrece un informe de antibiograma (sensibilidad o resistencia del patógeno frente a un antibiótico) al médico o médica que ha solicitado el análisis de la muestra microbiológica.
«Será este especialista el que ajuste el tratamiento del paciente en función del patógeno al que hemos puesto nombre y apellido. Es la mejor estrategia para evitar posibles complicaciones de la enfermedad, más aún en pacientes de riesgo con patologías previas o inmunodepresión«, destaca la Dra. Semiglia Chong.
Pero es el síndrome respiratorio agudo grave (SARS-CoV-2) el que se ha convertido en el protagonista de la neumonía desde finales de 2019 debido a su capacidad de infección: se apunta a día de hoy más de 56 millones de contagios y alrededor de 1.341.000 muertes a nivel mundial.
En países como España las personas afectadas por la covid-19 superan el 1.510.000, con una mortalidad superior a 42.000, más hombres que mujeres. Las últimas estadísticas publicadas a través de RENAVE (Red Nacional de Vigilancia Epidemiológica) nos informan de que en el periodo de 10 de mayo a 11 de noviembre:
- Un 5,5% de las personas diagnosticadas han sido hospitalizadas (de 1.174.807 casos, de los cuales un 0,4% han sido tratadas en UCI y un 0,9% han fallecido).
- La mayor proporción de casos se producen en el grupo de 15 a 59 años (68% del total), siendo el grupo de 15-29 años el más representado, con un 21% de los casos.
- El 52% de los casos covid son mujeres y la mediana de edad de los casos es de 40 años.
- El porcentaje de hospitalizaciones y defunciones aumenta con la edad, alcanzando un 26,2% y un 9,8% en mayores de 79 años, respectivamente.
- El ámbito más frecuente de exposición al coronavirus se da en el entorno del domicilio (31,6%).
Aún así, también los virus de la gripe (Influenzae A, B y C), el virus respiratorio sincitial o VRS (Mixovirus de la familia Pneumovirus), el SARS y el MERS son otros agentes sistemáticos que favorecen la aparición de la neumonía.
Los virus no se observan al microscopio, ya que no se pueden cultivar, y se tienen que diagnosticar microbiológicamente mediante técnicas moleculares basadas en el material genético del patógeno. La más relevante y sensible es la PCR (reacción en cadena de la polimerasa).

«Esta prueba se basa en la amplificación de una región específica DNA o RNA del microorganismo analizado. El proceso es complejo y lo debe efectuar personal cualificado«, recalca la doctora Cardeñoso Domingo.
En este sentido, RENAVE informa de que el 91,4% de los diagnósticos de coronavirus se han realizado con técnicas de PCR y un 8,4% por técnicas de detección de antígeno.
Desde el inicio de la pandemia, teniendo en cuenta que los datos no son definitivos y los contagios continúan acrecentando la curva, se han efectuado más de 16.200.000 pruebas diagnósticas (822.000 PCR solo entre el seis y el doce de noviembre de 2020). La tasa acumulada de pruebas diagnósticas durante todo este periodo pandémico es prácticamente de 344 por cada 1.000 habitantes.

«Los virus necesitan una célula de otro ser vivo para aprovecharse de su material molecular y poder replicarse, puesto que los virus son acelulares y solo cuentan con un ácido nucleico de ADN o ARN, ya sea de cadena simple o doble», explica la doctora y microbióloga Nelly Daniela Zurita.
«Para hacer una PCR a un virus, o a ciertas bacterias de difícil cultivo -expone-, procedemos a la extracción y purificación de sus ácidos nucleicos. A continuación, se lleva a cabo la amplificación logarítmica de las regiones específicas del microorganismo».
«Si en la gráfica final se muestran los fragmentos del material genético del virus se confirma la existencia del patógeno en la muestra biológica», señala.
«De un resultado negativo de la PCR se puede deducir que la muestra no se habría recogido con todas las garantías procedimentales o que en ese momento el virus todavía no se habría reproducido lo suficiente en el tejido respiratorio del paciente -falso negativo-«, aclara.
El procedimiento completo se lleva a cabo de manera manual o automatizada, y, dependiendo de los equipos utilizados, el resultado puede tardar desde 2 a 7 horas aproximadamente.
Una de las PCR más empleadas en el diagnóstico del SARS-CoV-2 es la PCR a tiempo real. Esta técnica utiliza la fluorescencia para monitorizar la amplificación del material genético del virus, de modo que un aumento de fluorescencia por encima de un umbral se considerará un resultado positivo de detección del virus .
«El estrés temporal de la covid-19 nos ha obligado a reinventarnos y ofrecer a la sociedad un plus de eficacia dado que las muestras que nos llegan al laboratorio han aumentado enormemente y cada paciente necesita una respuesta urgente», nos cuenta la doctora Laura Cardeñoso Domingo.
«El tiempo es oro ante cualquier enfermedad o durante cualquier pandemia, pero lo es más aún en tiempos del coronavirus. Es la clave para tomar una decisión clínica sobre un paciente que requiere un ingreso hospitalario o decidir si una persona debe confinarse en casa después de una toma de muestras en un Centro de Salud», establece.
Además, en el Hospital de La Princesa de Madrid, toda la capacidad analítica de su robótica está dedicada en un 100% al servicio de l@s pacientes. Analizan a diario paquetes de aproximadamente 1.600 muestras. Es un ejemplo más de nuestra razón de ser, la salud de la población», destaca.

Debe estar conectado para enviar un comentario.